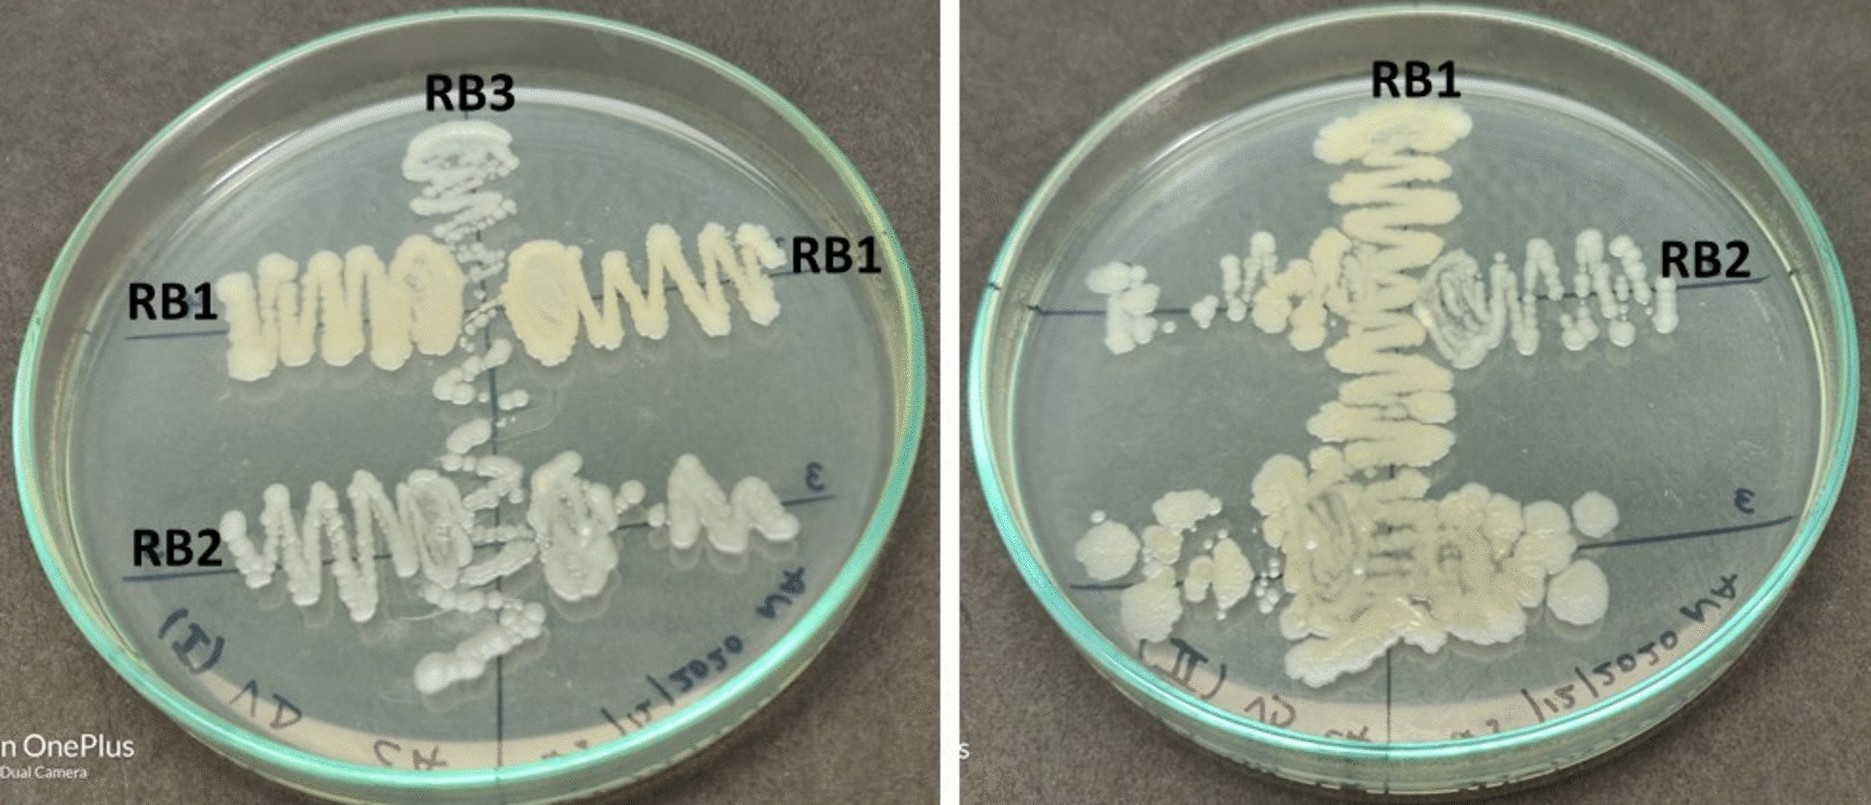
Fig. 1

Fig. 1

Compatibility test within the isolates showing synergistic effect on nutrient agar plate (RB1: Priestia aryabhattai; RB2: Bacillus pseudomycoides; RB3: Bacillus pumilus).
Compatibility test within the isolates showing synergistic effect on nutrient agar plate (RB1: Priestia aryabhattai; RB2: Bacillus pseudomycoides; RB3: Bacillus pumilus).